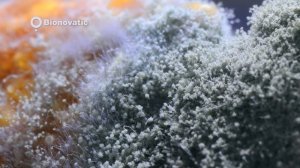
Микробиологические фунгициды 3.0

0:30
0:30
2022-03-11 18:13

 3:04
3:04

 3:04
3:04
2025-05-20 12:56

 2:57
2:57

 2:57
2:57
2024-09-01 09:15

 3:12
3:12

 3:12
3:12
2024-01-31 10:50

 2:20:14
2:20:14

 2:20:14
2:20:14
2025-01-29 19:53

 13:56
13:56

 13:56
13:56
2024-04-18 19:51

 1:51:24
1:51:24

 1:51:24
1:51:24
2024-10-30 07:05

 1:04
1:04

 1:04
1:04
2024-03-31 05:53

 4:44
4:44

 4:44
4:44
2024-09-26 18:51

 1:31
1:31

 1:31
1:31
2024-05-10 05:07

 7:04
7:04

 7:04
7:04
2023-12-10 11:02

 2:15
2:15

 2:15
2:15
2022-03-14 16:33

 3:30
3:30

 3:30
3:30
2022-03-11 11:19

 42:28
42:28

 42:28
42:28
2023-06-02 20:21

 2:14
2:14

 2:14
2:14
2022-09-04 15:20

 4:58
4:58

 4:58
4:58
2023-08-01 12:36

 2:21
2:21

 2:21
2:21
2023-06-30 09:40

 1:19
1:19
![Шерзодбек Жонибеков - Дадажон (Премьера клипа 2025)]() 3:02
3:02
![Мужик из СИБИРИ (Александр Конев) - Не прощу (Премьера клипа 2025)]() 2:39
2:39
![Alex Lim, Игорь Крутой - Вокзал (Премьера клипа 2025)]() 3:32
3:32
![Любовь Попова - Прощай (Премьера клипа 2025)]() 3:44
3:44
![Сергей Завьялов - В дороге (Премьера клипа 2025)]() 3:14
3:14
![Tural Everest, Baarni - Ушедший покой (Премьера клипа 2025)]() 3:01
3:01
![Рейсан Магомедкеримов, Ренат Омаров - Бла-та-та (Премьера клипа 2025)]() 2:26
2:26
![Ислам Итляшев - Не вспоминай (Премьера клипа 2025)]() 2:52
2:52
![Гор Мартиросян - 101 роза (Премьера клипа 2025)]() 4:26
4:26
![Жасурбек Мирзажонов - Суймаганга суйкалдим (Премьера клипа 2025)]() 5:45
5:45
![Руслан Гасанов, Роман Ткаченко - Друзьям (Премьера клипа 2025)]() 3:20
3:20
![Tural Everest - Ночной город (Премьера клипа 2025)]() 3:00
3:00
![Зафар Эргашов & Фируз Рузметов - Лабларидан (Премьера клипа 2025)]() 4:13
4:13
![Зара - Танго о двух влюбленных кораблях (Премьера клипа 2025)]() 3:10
3:10
![Светлана Ларионова - Осень отстой (Премьера клипа 2025)]() 3:30
3:30
![Алмас Багратиони - Сила веры (Премьера клипа 2025)]() 3:18
3:18
![Сардор Расулов - Етолмадим (Премьера клипа 2025)]() 4:15
4:15
![Дана Лахова - Одинокая луна (Премьера клипа 2025)]() 2:15
2:15
![MEDNA - Алё (Премьера клипа 2025)]() 2:28
2:28
![Алибек Казаров - Чужая жена (Премьера клипа 2025)]() 2:37
2:37
![Тот самый | Him (2025)]() 1:36:20
1:36:20
![Дом из динамита | A House of Dynamite (2025)]() 1:55:08
1:55:08
![Кей-поп-охотницы на демонов | KPop Demon Hunters (2025)]() 1:39:41
1:39:41
![Когда ты закончишь спасать мир | When You Finish Saving the World (2022)]() 1:27:40
1:27:40
![Хани, не надо! | Honey Don't! (2025)]() 1:29:32
1:29:32
![Псы войны | Hounds of War (2024)]() 1:34:38
1:34:38
![Обитель | The Home (2025)]() 1:34:43
1:34:43
![Терминатор 2: Судный день | Terminator 2: Judgment Day (1991) (Гоблин)]() 2:36:13
2:36:13
![Рука, качающая колыбель | The Hand That Rocks the Cradle (2025)]() 1:44:57
1:44:57
![Девушка из каюты №10 | The Woman in Cabin 10 (2025)]() 1:35:11
1:35:11
![Пойман с поличным | Caught Stealing (2025)]() 1:46:45
1:46:45
![Хищник | Predator (1987) (Гоблин)]() 1:46:40
1:46:40
![Чумовая пятница 2 | Freakier Friday (2025)]() 1:50:38
1:50:38
![Непрощённая | The Unforgivable (2021)]() 1:54:10
1:54:10
![Школьный автобус | The Lost Bus (2025)]() 2:09:55
2:09:55
![Французский любовник | French Lover (2025)]() 2:02:20
2:02:20
![Свинтусы | The Twits (2025)]() 1:42:50
1:42:50
![Богомол | Samagwi (2025)]() 1:53:29
1:53:29
![Заклятие 4: Последний обряд | The Conjuring: Last Rites (2025)]() 2:15:54
2:15:54
![Никто 2 | Nobody 2 (2025)]() 1:29:27
1:29:27
![Простоквашино. Финансовая грамотность]() 3:27
3:27
![Шахерезада. Нерассказанные истории Сезон 1]() 23:53
23:53
![Енотки]() 7:04
7:04
![Сборники «Зебра в клеточку»]() 45:30
45:30
![Умка]() 7:11
7:11
![Панда и Антилопа]() 12:08
12:08
![Люк - путешественник во времени]() 1:19:50
1:19:50
![Мультфильмы военных лет | Специальный проект к 80-летию Победы]() 7:20
7:20
![Пип и Альба. Приключения в Соленой Бухте! Сезон 1]() 11:02
11:02
![Врумиз. 1 сезон]() 13:10
13:10
![Лудлвилль]() 7:09
7:09
![Монсики]() 6:30
6:30
![Истории Баданаму Сезон 1]() 10:02
10:02
![Паровозик Титипо]() 13:42
13:42
![Простоквашино]() 6:48
6:48
![Команда Дино. Исследователи Сезон 1]() 13:10
13:10
![Новогодние мультики – Союзмультфильм]() 7:04
7:04
![Синдбад и семь галактик Сезон 1]() 10:23
10:23
![Минифорс. Сила динозавров]() 12:51
12:51
![Чуч-Мяуч]() 7:04
7:04

 1:19
1:19Скачать видео
| 256x144 | ||
| 640x360 | ||
| 856x480 | ||
| 1280x720 |
 3:02
3:02
2025-10-25 13:03
 2:39
2:39
2025-10-30 11:00
 3:32
3:32
2025-10-31 15:50
 3:44
3:44
2025-10-21 09:25
 3:14
3:14
2025-10-29 10:28
 3:01
3:01
2025-10-31 13:49
 2:26
2:26
2025-10-22 14:10
 2:52
2:52
2025-10-28 10:47
 4:26
4:26
2025-10-25 12:55
 5:45
5:45
2025-10-27 13:06
 3:20
3:20
2025-10-25 12:59
 3:00
3:00
2025-10-28 11:50
 4:13
4:13
2025-10-29 10:10
 3:10
3:10
2025-10-27 10:52
 3:30
3:30
2025-10-24 11:42
 3:18
3:18
2025-10-24 12:09
 4:15
4:15
2025-10-26 12:52
 2:15
2:15
2025-10-22 14:16
 2:28
2:28
2025-10-21 09:22
 2:37
2:37
2025-10-30 10:49
0/0
 1:36:20
1:36:20
2025-10-09 20:02
 1:55:08
1:55:08
2025-10-29 16:30
 1:39:41
1:39:41
2025-10-29 16:30
 1:27:40
1:27:40
2025-08-27 17:17
 1:29:32
1:29:32
2025-09-15 11:39
 1:34:38
1:34:38
2025-08-28 15:32
 1:34:43
1:34:43
2025-09-09 12:49
 2:36:13
2:36:13
2025-10-07 09:27
 1:44:57
1:44:57
2025-10-29 16:30
 1:35:11
1:35:11
2025-10-13 12:06
 1:46:45
1:46:45
2025-10-02 20:45
 1:46:40
1:46:40
2025-10-07 09:27
 1:50:38
1:50:38
2025-10-16 16:08
 1:54:10
1:54:10
2025-08-27 17:17
 2:09:55
2:09:55
2025-10-05 00:32
 2:02:20
2:02:20
2025-10-01 12:06
 1:42:50
1:42:50
2025-10-21 16:19
 1:53:29
1:53:29
2025-10-01 12:06
 2:15:54
2:15:54
2025-10-13 19:02
 1:29:27
1:29:27
2025-09-07 22:44
0/0
 3:27
3:27
2024-12-07 11:00
2021-09-22 23:25
 7:04
7:04
2022-03-29 18:22
 45:30
45:30
2025-09-17 18:49
 7:11
7:11
2025-01-13 11:05
 12:08
12:08
2025-06-10 14:59
 1:19:50
1:19:50
2024-12-17 16:00
 7:20
7:20
2025-05-03 12:34
2021-09-22 23:36
2021-09-24 16:00
 7:09
7:09
2023-07-06 19:20
 6:30
6:30
2022-03-29 19:16
2021-09-22 21:29
 13:42
13:42
2024-11-28 14:12
 6:48
6:48
2025-10-17 10:00
2021-09-22 22:45
 7:04
7:04
2023-07-25 00:09
2021-09-22 23:09
 12:51
12:51
2024-11-27 16:39
 7:04
7:04
2022-03-29 15:20
0/0

